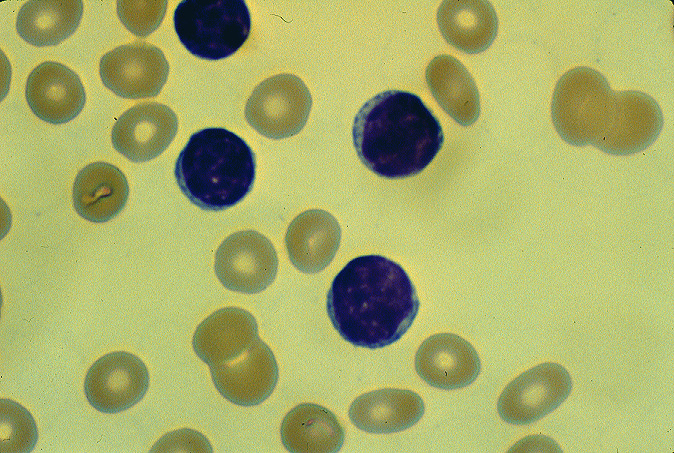

Small lymphocyte, peripheral blood
Click picture to enlarge. Close window to return
B and T lymphocytes are morphologically identical. A fluorescent antibody to a specific cluster designation (CD) is used to define lymphocyte subpopulations. For example, CD4 positive cells are T-helper cells and CD8 positive cells are T-suppressor.This is done with laser light in an instrument called a flow cytometer, because it records the size and fluorescent signature of each cell as it flows by a sensor.